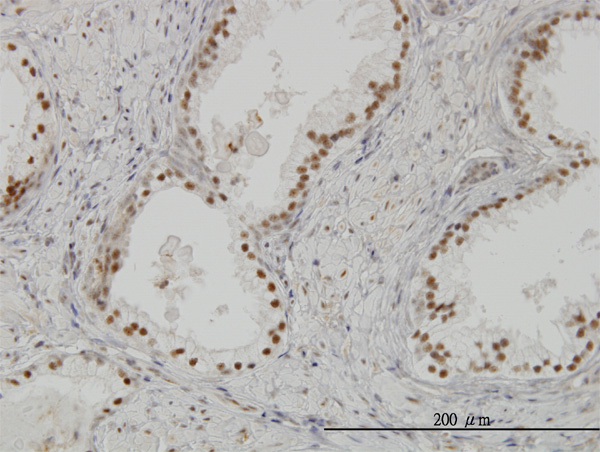

> Antigen, Antibodies, ELISA, Western Blot > Primary Antibody > Monoclonal Antibodies > CLK3 Antibody (monoclonal) (M07)Brand |
Leading Biology | Catalog Number |
AMM03398G |
Product Type |
Monoclonal Antibodies | Field of Research |
|
Product Overview |
We constantly strive to ensure we provide our customers with the best antibodies. As a result of this work we offer this antibody in purified format.
We are in the process of updating our datasheets. If you have any questions regarding this update, please feel free to contact our technical support team.
This product is a high quality CLK3 Antibody (monoclonal) (M07).
|
||
Molecular Weight |
73515 Da
|
||
Host |
mouse
|
||
Species Reactivity |
Human
|
||
Target |
CLK3 (AAH02555, 36 a.a. ~ 136 a.a) partial recombinant protein with GST tag. MW of the GST tag alone is 26 KDa.
|
||
Clone |
7D6
|
||
Isotype |
IgG2b Kappa
|
||
GeneID |
|||
UniProt ID |
|||
Summary |
This gene encodes a protein belonging to the serine/threonine type protein kinase family. This protein is a nuclear dual-specificity kinase that regulates the intranuclear distribution of the serine/arginine-rich (SR) family of splicing factors. Two transcript variants encoding different isoforms have been found for this gene. Related pseudogenes are located on chromosomes 1 and 9.
|
||
Storage & Stability |
Store at +4°C short term. For long-term storage, aliquot and store at -20°C or below. Stable for 12 months at -20°C. Avoid repeated freeze-thaw cycles.
|
||
Applications |
WB, IHC, IF
|
||
Dilution |
WB~~1:500~1000
|
||
Images |

Antibody Reactive Against Recombinant Protein.Western Blot detection against Immunogen (36.74 KDa) . 
CLK3 monoclonal antibody (M07), clone 7D6 Western Blot analysis of CLK3 expression in MCF-7 ( AMM03398G )
Immunoperoxidase of monoclonal antibody to CLK3 on formalin-fixed paraffin-embedded human prostate. [antibody concentration 3 ug/ml] |
||
Specification |
|||
Quantity |
|
||
| Select | Brand | Catalog No. | Product Name | Pack Size | Type | Field of Research | Specification | Quantity | Price(USD) | |
| 1 | Leading Biology | APG02467G | CCK4 / PTK7 Antibody (clone 4F9) | 50 μl | Monoclonal Antibodies |
|
$495.00 | Add Ask | ||
| 2 | Leading Biology | AMM04683G | GALT Antibody (clone 4C11) | 50 μg | Monoclonal Antibodies |
|
$545.00 | Add Ask | ||
| 3 | Leading Biology | AMM01402G | Vimentin (Mesenchymal Cell Marker) Antibody - With BSA and Azide | 50 ug | Monoclonal Antibodies |
|
$395.00 | Add Ask | ||
| 4 | Leading Biology | APR08280G | LTA4H / LTA4 Antibody (clone 9G8) | 50 μl | Monoclonal Antibodies |
|
$495.00 | Add Ask | ||
| 5 | Leading Biology | AMM00172G | CD1a / HTA1 (Mature Langerhans Cells Marker) Antibody - With BSA and Azide | 50 ug | Monoclonal Antibodies |
|
$395.00 | Add Ask | ||
| 6 | Leading Biology | AMM05750G | CEBPA Antibody | 100 μl | Monoclonal Antibodies |
|
$545.00 | Add Ask |
 Leading Biology Inc.
2600 Hilltop DR, Building G, B Suite C138
Richmond, CA, 94806
Tel: 1-661-524(LBI)-0262
Email: info@leadingbiology.com
Leading Biology Inc.
2600 Hilltop DR, Building G, B Suite C138
Richmond, CA, 94806
Tel: 1-661-524(LBI)-0262
Email: info@leadingbiology.com
Complete this form and click send to ask us a question, request a quote or simply say hello.

You have 0 item in your cart

You have 0 item in your inquiry list
